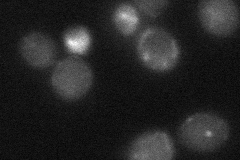

View description
Protein that forms a complex with Kar3p at the spindle pole body, possible regulator of Kar3p function in microtubule-mediated processes; required for sister chromatid cohesion; has similarity to Cik1p
Localization:
Intensity:
Fold change:
Significance:
-
C’ GFP library in SD

nucleus177.33 -
N' NOP1pr-GFP in SD

cytosol,punctate41.2367 -
N' TEF2pr-mCherry in SD

punctate26.1898 -
N' NATIVEpr-GFP in SD

punctate19.8337 -
N' TEF2pr-VC and Cyto-VN in SD
below threshold25.0574 -
C’ GFP library in SD+DTT

nucleus139.320.78No -
C’ GFP library in SD+H2O2

nucleus202.221.14No -
C’ GFP library in Starvation Media

punctate, nucleusN/AN/AYes -
C’ GFP library on the background of Pup2-DaMP

nucleus -
C’ GFP library on the background of CCT mutant

nucleus182.5951.02964No
